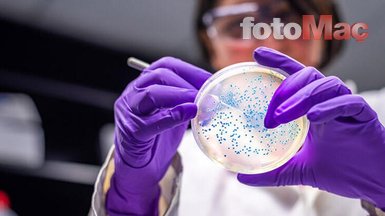

Son dakika corona virüsü haberi: 'Virüs kasten üretildi elimizde deliller var'

ABD Dışişleri Bakanı Mike Pompeo, yeni tip corona virüs (covid-19) virüsünün Çin'in Wuhan kentinde bulunan laboratuvardan çıktığına dair çok sayıda delil olduğunu ileri sürdü.

Pompeo, Çin yönetiminin uluslararası ajanslarda çalışan gazetecileri ülkeden atıp, uyarılarda bulunan Çinli doktorları susturmak suretiyle Wuhan'da ortaya çıkan virüsün gizli kalması için uğraştığını ve bunun dünya genelinde yüz binlerce insanı etkilediğini vurguladı.